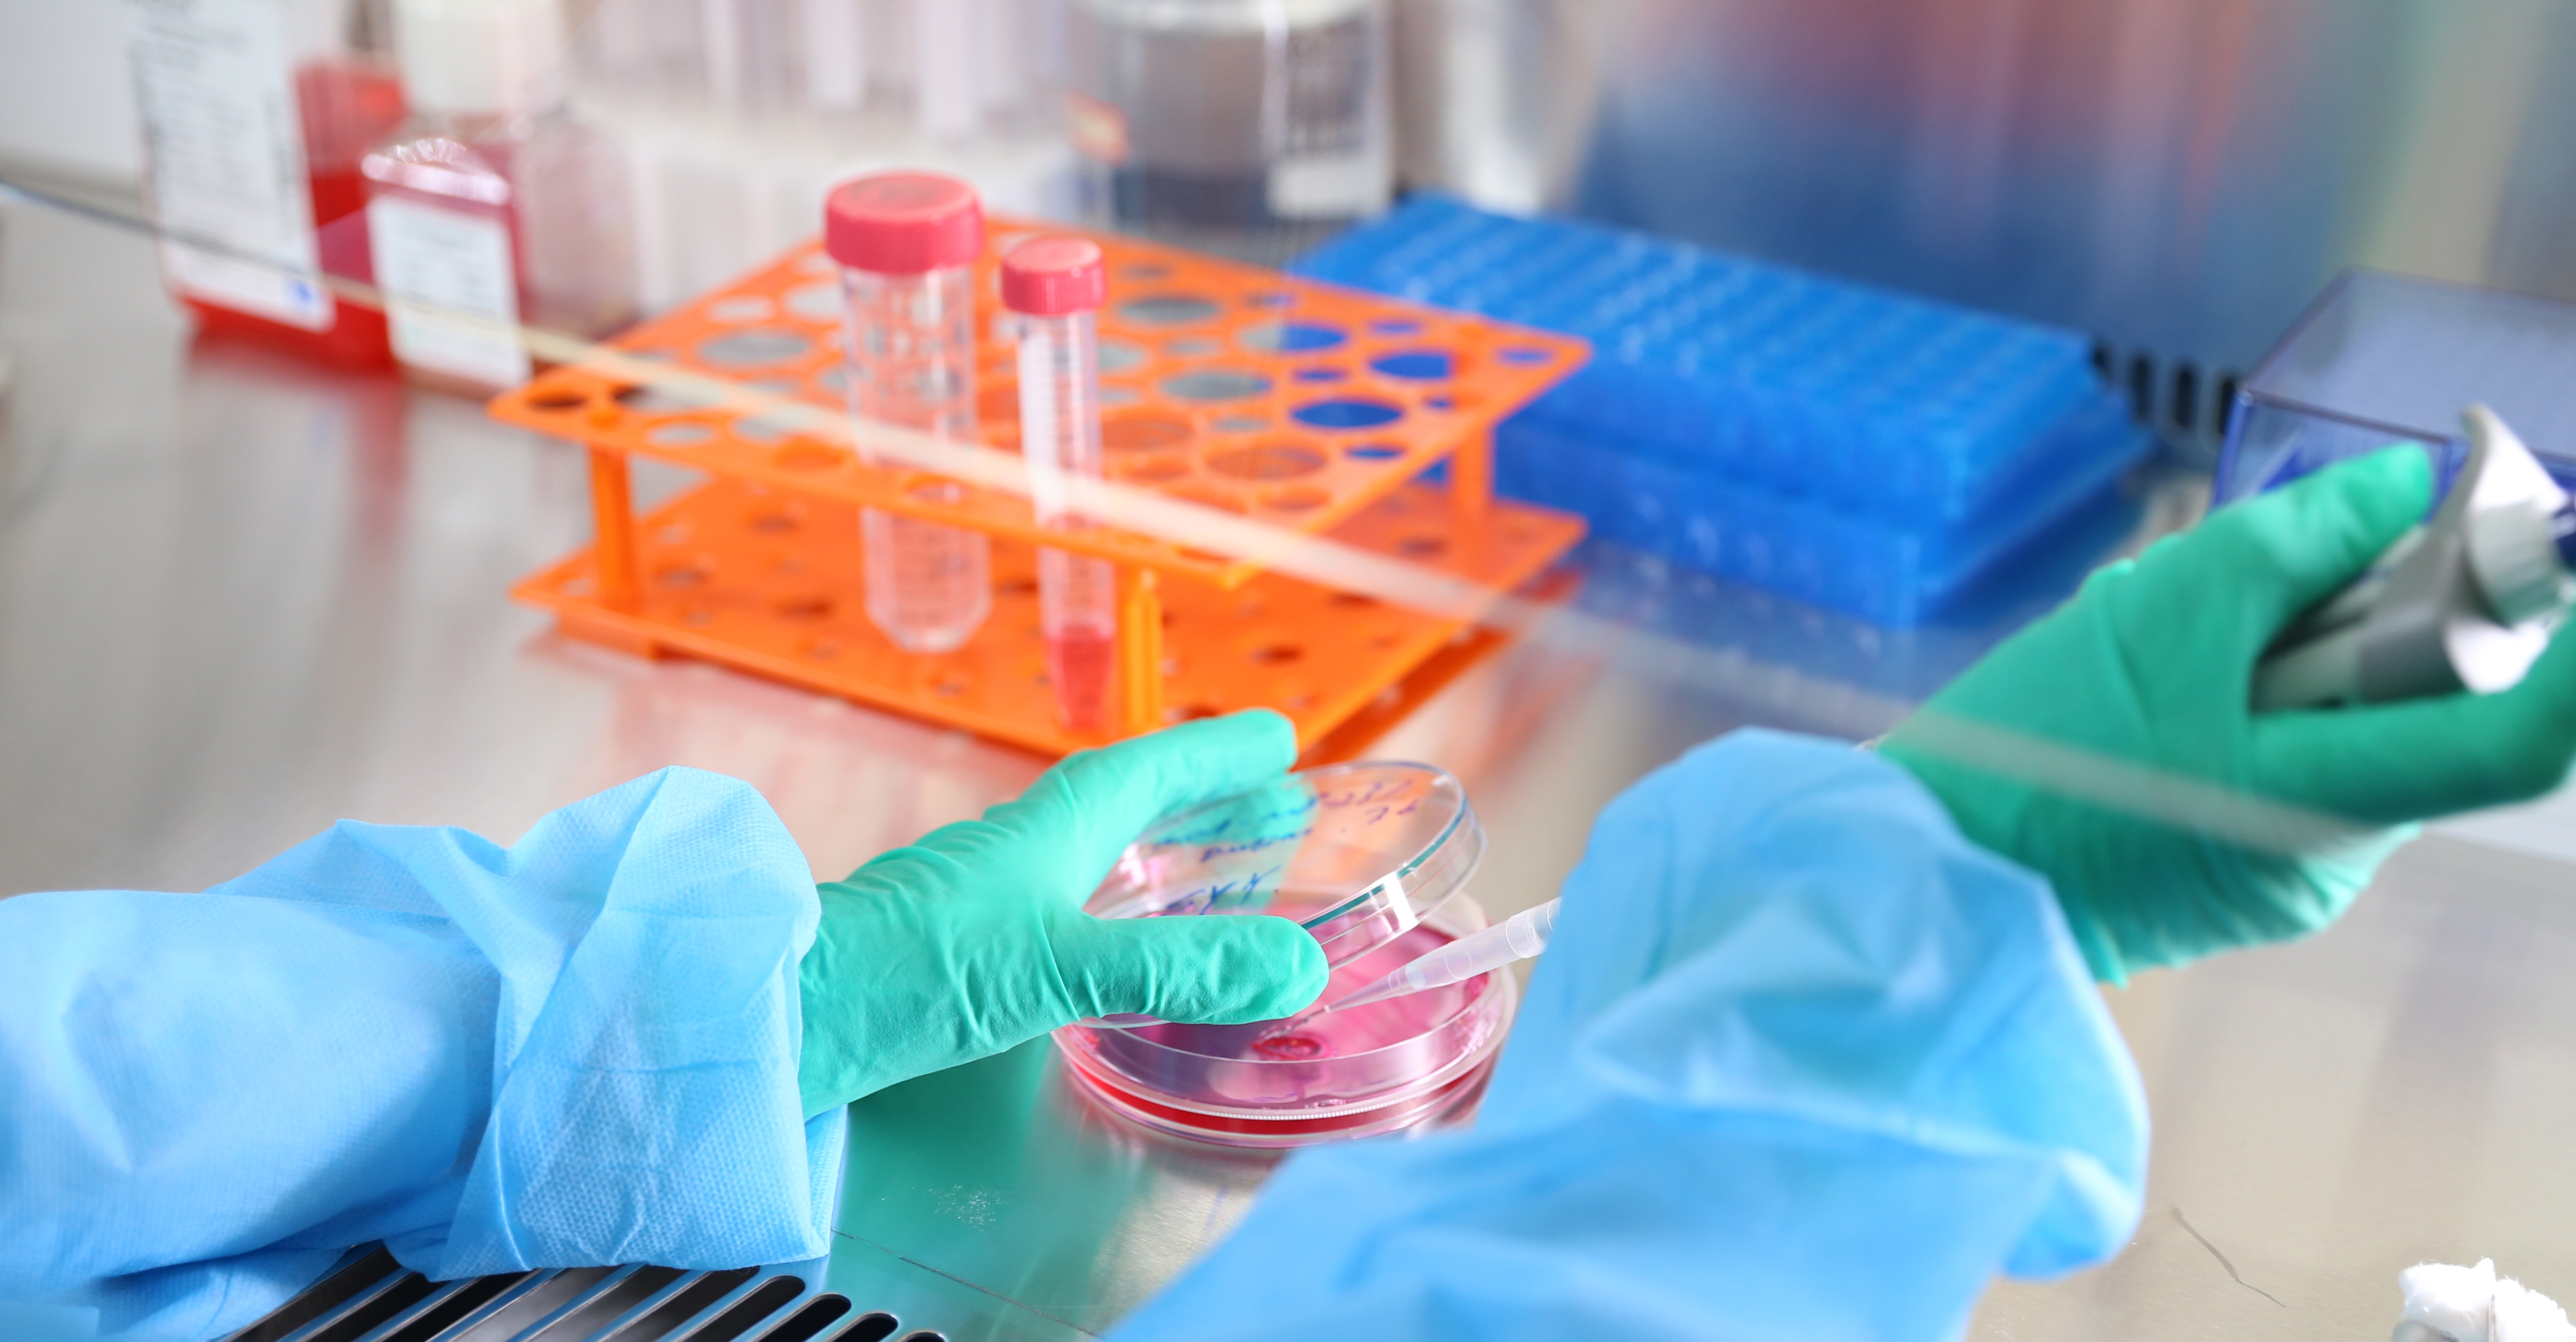

New Customers Sepcial: Get 15% off, use the code "NEW15" at checkout. Shop Now!
What We Offer
In Tridix Bio, we are building a revolutionary in vitro platform that accelerates new drug development by integrating cutting-edge 3D cellular models, AI-driven protein engineering, and precision cell detection technologies. This comprehensive system enables more predictive, scalable, and efficient solutions for drug discovery and translational research.

About Us
Headquartered in the biotech hub of San Diego, Tridix Bio is dedicated to accelerating drug development and biomedical research through its proprietary in vitro technologies. Our platform spans advanced 3D cellular modeling, in vitro testing and screening, AI-driven protein engineering, and precision cell detection solutions. Trdix is always open to collaboration and committed to driving innovation together with our partners.
Why Choose Us
Tridix Bio is the ideal partner for advancing your research and development goals. We combine cutting-edge technologies with a highly experienced scientific team to deliver innovative, reliable solutions. Our client-centric approach ensures perrsonalized support, and our flexible business models make collaboration seamless and scalable to your needs.
Cutting-Edge Technologies
Proprietary platforms in 3D cellular modeling, AI-driven protein engineering, and precision cell detection.
Experienced Scientific Team
Our team offers deep expertise in drug discovery and in vitro systems, delivering reliable, science-driven results.
Client-Centric Approach
Tailored solutions and responsive support throughout the collaboration.
Flexible Business Models
Scalable and adaptable partnership structures to meet diverse project needs.